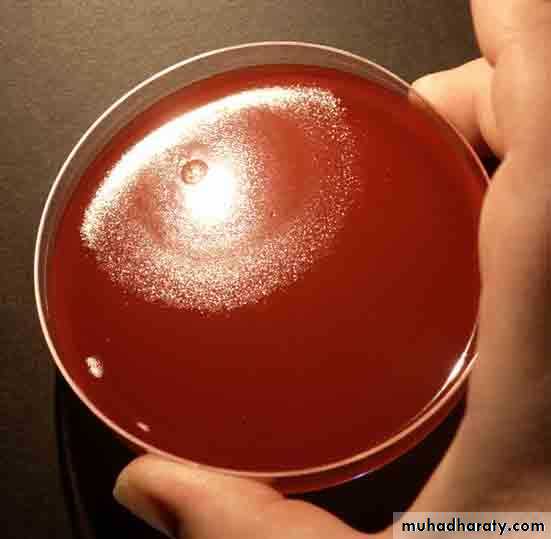
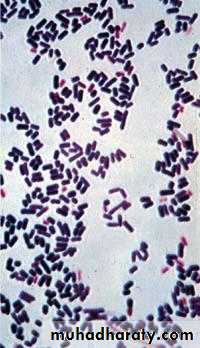
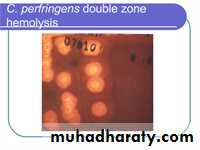

Genus Clostridium
المرحلة الثالثة
جراثيمالعدد
12/12/2018
تسلسل 31
General characteristics
Members of the genus Clostridium are classified based on morphology, physiology, DNA relatedness.More than 100 spp.
Members of the Genus Clostridium are Gram-positive rods, form endospores, are anaerobic.
Their natural habitat is the soil and the intestinal tract of human and animals as saprophytic.
General characteristics
The sporulation makes these organisms extremely resistant to disinfectants and drying. These spores may allow the organisms to persist in the environment for years.They do not create energy by oxidizing sugars to water and carbon dioxide.
General characteristics
Clostridia are able to ferment a wide variety of organic compounds.
They produce end products such as butyric acid, acetic acid, butanol and acetone, and large amounts of gas (CO2 and H2) during fermentation of sugars.
A variety of foul smelling compounds are formed during the fermentation of amino acids and fatty acids.
They may be saccharolytic or proteolytic and are usually catalase and oxidase negative.
General characteristics
All pathogenic clostridia species produce exotoxins which play a central role in the organism’s pathogenesisVirtually all members of the genus, except Clostridium perfringens, are motile with peritrichous flagellae.
Clostridium tetani
Microscopical appearanceGram positive slender rods straight or slightly curved.
Spores are circular, terminal and bulging (drum stick)
Motile and non-capsulated
Cultural characteristics:diaphanous growth on blood agar.
Biochemical reaction
Slightly proteolytic.Antigenic structure
Flageller Ags (H Ag), 10 types,
All of them share a common somatic ( O) Ag.
Pathogenesis
Portal of entry is usually a wound.Neurotoxin, tetanospasmin (exotoxin) is produced by vegetative cells at wound site when spores germinate and vegetative cells grow. The organism multiplies locally and symptoms appear remote from the infection site.
The toxin is a polypeptide with mol. wt of 160 000 & consist of two subunits A & B.
Plasmid gene controls the production of tetanus toxin.
Pathogenesis:
Toxin is Initially binds to peripheral nerve terminalsTransported within the axon and across synaptic junctions until it reaches the central nervous system.
where it binds to ganglioside receptors & block the release of inhibitory mediators ( γ- aminobutyric acid and glycin) at spinal synapses which result in hyperreflexia & muscle spasm.
Cont,
The organism is non-invasive and thus remains in the local wound.Tetanus may follow burns, deep puncture wounds, ear or dental infections, animal bites, abortion
The toxin reaches CNS along the motor nerve trunk or through the blood.
Predisposing factors are necrotic tissue, presence of blood clot & lack of drainage, presence of foreign bodies & associated pyogenic infection
Clinical picture of tetanus
I.P ranges from 4-5 days to weeks & is influenced by:
1.site & nature of the wound
2.dose & toxigenicity of the m.o.
3.immune status of the patient.
Severe contraction of the muscles of the jaw which may be locked( trismus). This is a stiffness of the jaw muscles that results in inability to open the mouth or swallow leading to the appearance of a sardonic smile (risus sardonicus).
Cont,
Speech as a result of spasm of the vocal cords may be affected.If the muscle spasm affect the larynx or chest wall, they may cause asphyxiation
Contraction of the back muscles resulting in backward arching.
Death may occur when spasms interfere with respiration
Disease is usually self-limiting in adults with no neurological damage.
Tetanus neonatorum
In neonates, the average latent period is about a week.The predisposing factors may be unimmunized mother and lack of good hygiene during and after delivery.
The m.o. may enter through the umbilicus or the wound of circumcision . The baby stops nursing, becomes rigid, has convulsion and may die within days.
Tetanus
Lab diagnosis
The diagnosis is entirely clinical and does not depend upon bacteriologic confirmation.1.Direct microscopical examination is unreliable
2.Culture is positive only in 30% of cases.
3. Animal inoculation
Lab diagnosis
Test animal:Inoculation of suspension of the m.o. in the root of tail of a mouse. Then there will be stiffness of the tail, spastic paralysis of the hind limbs, trunk and the front limbs.
Control animal:
If this animal is inoculated with 1000 U of antitoxin one hr. earlier to injection of the toxin, this animal will remain alive.
Cont,
Prevention
Active immunization with the toxoid , part of DTP vaccine. The tetanus toxoid is a formalin-inactivated toxin, with an efficiency of approx. 100%.
Passive immunization with antitoxin immunoglobulin.
Good surgical debridement .
Good treatment of pyogenic infection of wound by proper use of antibiotics.
Treatment
Antitoxin immunoglobulin.Drug of choice is penicillin and metronidazole. The bacteria are killed with antibiotics, and further toxin production is thus prevented
Tranquilizers to prevent spasm.
C. perfringens
Spores are found in soil, dust and air.Non motile and capsulated.
Spores are rarely seen in clinical specimen but if present are large, central to subterminal & oval.
On blood agar, double zone hemolysis.
There are six strains of this m.o. (A-F), strain A is responsible for most of human infections.
Five toxins: α, β, epsilon, iota & enterotoxin.
Clostridium perfringens
C. perfringens
Clinical diseases caused by C. perfringens: 1. Gas gangrene
Gas gangrene can be caused by several spp. of clostridia such as C. septicum and C. novyi , but C. perfringens is the most common.Severe and open wounds, such as compound fractures and other ischemia producing injuries are predisposing conditions.
Gas gangrene occurs in an anaerobic environment created by poor blood flow to the wound.
I.P is less than 24 hrs, range 6hrs – several days.
This bacterium is an invasive pathogen that can gain access to traumatized tissues by contamination from dirt.
C. perfringens cells proliferate after spore germination occurs and they release their exotoxin.
Cont,
The organism produces several tissue degrading enzymes including proteases, DANase, lipase, collagenase, hyaluronidase and lecithinase (alpha toxin)Lecithinase causes lysis of endothelial cells, erythrocytes, leukocytes and platelets.
The toxins cause necrosis and destruction of blood vessels and the surrounding tissue, especially muscle producing bubbles of gas which can be felt in the tissue.
The organism can spread systemically.
If the toxin enter the blood , there is massive hemolysis, renal failure & death.
Clinical picture
Sudden onset of severe pain at site of injury.
The skin over the infected area may initially appear pale, the change to bronze then purplish red, becomes tense & tender, the overlying bullae may be red, blue or purple
Crepitation in the subcutaneous tissue and muscle, foul smelling discharge, rapidly progressing necrosis, fever, hemolysis, toxemia, shock, renal failure, and death.
Gas gangrene
Lab diagnosis
The diagnosis is mainly clinical.Direct gram stain: presence of bacilli in the wound is a definitive diagnosis. Boxcar shape bacilli with lack of inflammatory cells & presence of necrotic material.Culture: anaerobic culture on blood plate
The key reactions for identification of C. perfringens are the production of double hemolysis on blood agar,
the production of lecithinase on egg-yolk agar (precipitate formed around colonies on egg yolk media.
positive Nagler҆s reaction
& the stormy fermentation of litmus milk.
Treatment of gas gangrene
Antimicrobial therapy, penicillin, clindamycin, chlomphenicol, metronidazole.Aggressive surgical debridement.
Antitoxin therapy.
2. Food poisoning
Most cases are due to strain A.
Transmission is through the contamination of food with heat resistant spores that survive cooking , it germinate and multiply , reheating may not kill the organism that produce the toxin.
Food poisoning
The enterotoxin acts as a super-antigen, it disrupts ion transport by altering the membrane permeability.Is a self-limiting disease characterized by abdominal pain, diarrhea & vomiting after I.P. of 8-24 hrs.
Lab diagnosis of food poisoning
The diagnosis can be established by detection of C. perfringens enterotoxin in stool by commercially available kits.C. Botulinum
Clostridium botulinum
Mode of transmissionInadequate sterilization of canned vegetable and meat contaminated with the spores, the spores germinate and vegetative cells produce toxin.
Infant botulism, can occur when the m.o. elaborate the toxin after it has colonize the GIT of infant. It has been associated with feeding babies honey contaminated with C. botulinum spores.
Wound botulism is more rare, occurs when the toxin is produced from implanted organisms in a wound site.
C. botulinum
Pathogenesis and clinical picture:
Eight types of toxins (A-H).Types A, B & E are most common in human infections.
The neurotoxin is absorbed from the gut and is carried by blood to the peripheral nerve synapses where it block the release of acetyl choline leading to complete paralysis of essential muscles.
Clinical picture
After eating contaminated food, the symptoms of botulism occur usually with a day or two but sometimes there may be a period of up to a week before they appear.Muscle paralysis ensues, usually starting at the head.
There will be a descending weakness & paralysis.
Diplopia, dysphagia & respiratory failure.
Clinical picture
Infant botulismInfants develop paralysis or weakness.May need respiratory support.Usually recover spontaneously.
Lab diagnosis
Demonstration of neurotoxin in the feces, serum, gastric content, vomitus or suspect food by injecting samples into mice.Mice will die unless protected by antitoxin.
Cultural isolation of C. botulinum is rarely performed.
PCR for detecting toxin sequence
Treatment
Trivalent antitoxin (types A, B & E).Intensive respiratory support.
Antibiotics are not recommended.
Complete recovery may take months
Prevention
Proper sterilization of canned food.Storing food at < 4ᴼC
Adequate food cooking to inactivate the toxin.
Clostridium difficle
Is responsible for antibiotic-associated GIT disease ranging from mild diarrhea to life-threatening pseudomembranous colitis.
One of the most common nosocomial infection & is a frequent cause of morbidity & mortality among elderly hospitalized patients.
Mode of transmission
Spores of this m.o. are found in the environment, particularly in the hospital wards, nurseries & bathrooms.The m.o. is carried in the GIT in about 3% of general population and up to 30% of hospital patients.
Infection is acquired mainly by fecal-oral route.
It may occur after antimicrobial therapy particularly associated with ampicillin, cephalosporins, & clindamycin
Pathogenesis
C. Difficle produces two types of toxins A& BBoth toxins adhere to receptors on the human colon cells.
Toxin A is an enterotoxin which is a chemotactic for neutrophils & monocyte. Infiltration of the intestinal mucosa.
It cause an acute inflammatory diarrhea.
Toxin B is a cytotoxin that cause necrosis of the intestinal epithelium.
Clinical picture
Diarrhea may be associated with pseudomembranes ( yellow-white plaques) on the colonic mucosa.Is usually non-bloody.
Fever, abdominal cramps may occur.
Toxic megacolon may occur that may need surgical resection.
Colonoscopy
Lab Diagnosis
This pathogen is difficult to be cultured on conventional media.CCFA (cycloserine-cefoxitin-fructose agar) is a selective medium for C. difficle.
Diagnosis by detection of toxins in the stool .
Detection of toxin B by cytotoxic assay, the stool is added to a cell culture line usually fibroblasts. The toxin released by the bacteria exert a cytopathic effect characterized by rounding of the fibroblasts.Immunoassay of the stool for the presence of A & B toxins in the stool by ELISA.
Treatment
Drugs of choice is vancomycin and metronidazole.
Fluid replacement